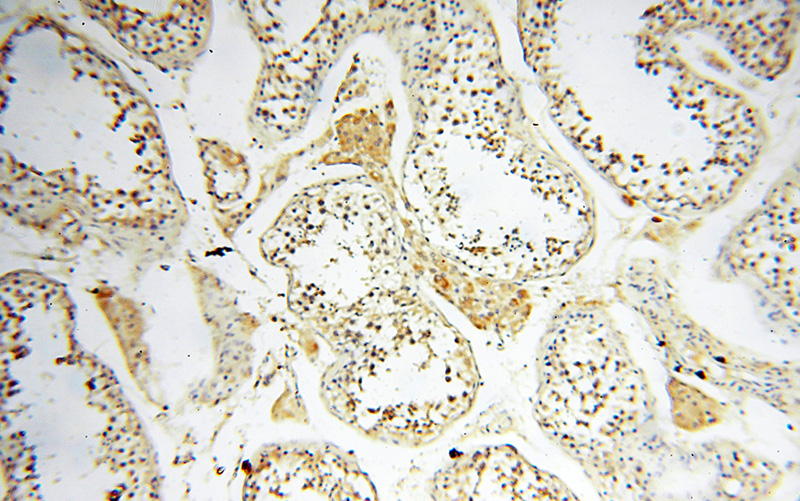
Immunohistochemical of paraffin-embedded human testis using Catalog No:107932(AKAP3 antibody) at dilution of 1:100 (under 10x lens)

-
Product Name
AKAP3 antibody
- Documents
-
Description
AKAP3 Rabbit Polyclonal antibody. Positive WB detected in mouse testis tissue. Positive IHC detected in human testis tissue, human heart tissue, human kidney tissue, human skin tissue. Observed molecular weight by Western-blot: 100 kDa
-
Tested applications
ELISA, WB, IHC
-
Species reactivity
Human,Mouse,Rat; other species not tested.
-
Alternative names
A kinase anchor protein 3 antibody; AKAP 110 antibody; AKAP 3 antibody; AKAP110 antibody; AKAP3 antibody; Cancer/testis antigen 82 antibody; CT82 antibody; Fibrousheathin 1 antibody; Fibrousheathin I antibody; FSP95 antibody; PRKA3 antibody; SOB1 antibody; Sperm oOCyte binding protein antibody
-
Isotype
Rabbit IgG
-
Preparation
This antibody was obtained by immunization of AKAP3 recombinant protein (Accession Number: NM_006422). Purification method: Antigen affinity purified.
-
Clonality
Polyclonal
-
Formulation
PBS with 0.02% sodium azide and 50% glycerol pH 7.3.
-
Storage instructions
Store at -20℃. DO NOT ALIQUOT
-
Applications
Recommended Dilution:
WB: 1:1000-1:10000
IHC: 1:20-1:200
-
Validations

mouse testis tissue were subjected to SDS PAGE followed by western blot with Catalog No:107932(AKAP3 antibody) at dilution of 1:5000
Immunohistochemical of paraffin-embedded human testis using Catalog No:107932(AKAP3 antibody) at dilution of 1:100 (under 10x lens)

Immunohistochemical of paraffin-embedded human testis using Catalog No:107932(AKAP3 antibody) at dilution of 1:100 (under 40x lens)
-
Background
AKAP3 is a member of A-kinase anchoring proteins (AKAPs), a family of functionally related proteins that target protein kinase A to discrete locations within the cell. AKAP3 is reported to participate in protein-protein interactions with the R-subunit of the protein kinase A as well as sperm-associated proteins. AKAP3 is expressed in spermatozoa and localized to the acrosomal region of the sperm head as well as the length of the principal piece. It may function as a regulator of motility, capacitation, and the acrosome reaction.
-
References
- Fatima S, Wagstaff KM, Loveland KL, Jans DA. Interactome of the negative regulator of nuclear import BRCA1-binding protein 2. Scientific reports. 5:9459. 2015.
Related Products / Services
Please note: All products are "FOR RESEARCH USE ONLY AND ARE NOT INTENDED FOR DIAGNOSTIC OR THERAPEUTIC USE"
